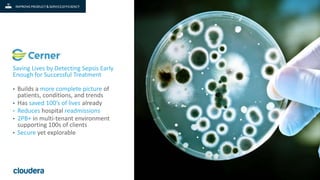
5© Cloudera, Inc. All rights reserved.
Saving Lives by Detecting Sepsis Early
Enough for Successful Treatment
• Builds a more complete picture of
patients, conditions, and trends
• Has saved 100’s of lives already
• Reduces hospital readmissions
• 2PB+ in multi-tenant environment
supporting 100s of clients
• Secure yet explorable

The document discusses how data has become a strategic asset for businesses and how a modern data platform can help organizations drive customer insights, improve products and services, lower business risks, and modernize IT. It provides examples of companies using analytics to personalize customer solutions, detect sepsis early to save lives, and protect the global finance system. The document also outlines the evolution of Hadoop platforms and how Cloudera Enterprise provides a common workload pattern to store, process, and analyze data across different workloads and databases in a fast, easy, and secure manner.